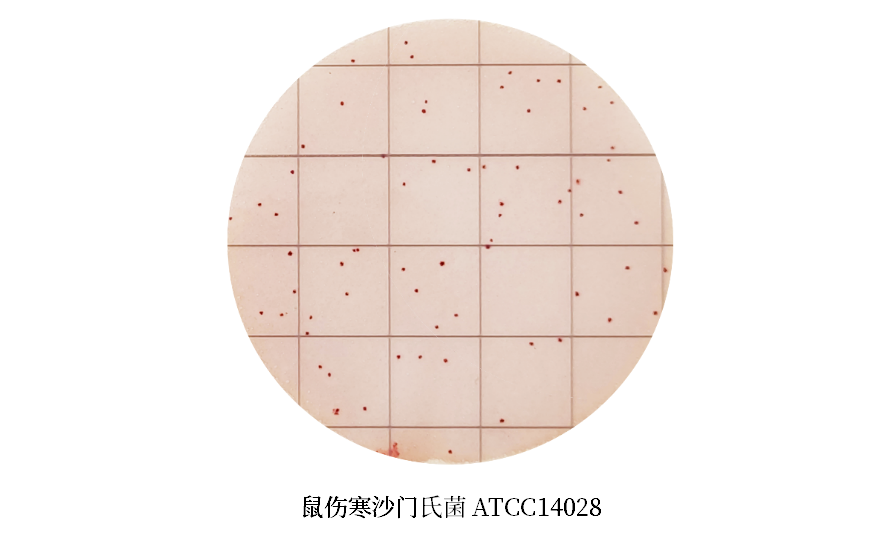
陸橋推出新大腸菌群測試片：符合GB4789.3-2025

? ? ? ? 2025版大腸菌群計數(shù)標準于2025年3月16日頒布,其中新增了大腸菌群計數(shù)測試片,并對該方法的原理進行了描述:應(yīng)以發(fā)酵乳糖產(chǎn)酸產(chǎn)氣為陽性結(jié)果判斷依據(jù),且性能符合 GB 4789.28中相關(guān)培養(yǎng)基的質(zhì)量要求。
我公司針對新標準中大腸菌群計數(shù)測試片的原理研發(fā)了相應(yīng)的測試片—Numbio Plate?大腸菌群測試片,產(chǎn)品貨號:NBP002。其主要成分與GB 4789.3-2025《食品安全國家標準 食品微生物學(xué)檢驗 大腸菌群計數(shù)》中結(jié)晶紫中性紅膽鹽瓊脂培養(yǎng)基(VRBA)主要成分一致。微生物生長后可直接觀察產(chǎn)氣,無需確認試驗。

產(chǎn)品特點
配方一致:測試片基于VRBA改良,其主要營養(yǎng)成分與VRBA配方一致;
操作簡單:測試片無需壓板,樣液加入后直接蓋膜即可自由擴散;
容易判讀:目標菌紅色帶氣泡,非目標菌被抑制或不產(chǎn)氣;
節(jié)省時間:18 h~24?h即可確認陽性菌落,無需確認試驗,比傳統(tǒng)方法節(jié)省24 h~48 h;
適用性廣:適用于各類食品及食品原料中大腸菌群的計數(shù);
結(jié)果準確:經(jīng)大量樣品及標準菌株驗證試驗,結(jié)果與VRBA無顯著性差異。
質(zhì)量控制

GB 4789.28-2024《食品安全國家標準 食品微生物學(xué)檢驗 培養(yǎng)基和試劑的質(zhì)量要求》中VRBA的質(zhì)控要求

陸橋Numbio Plate?大腸菌群測試片在滿足GB 4789.28對VRBA質(zhì)控要求的同時,經(jīng)大量樣品及標準菌株驗證試驗,其結(jié)果與VRBA無顯著性差異。該產(chǎn)品操作簡單,省去傳統(tǒng)培養(yǎng)基的繁瑣配制和后續(xù)瓊脂恒溫等過程。判讀容易,可直接觀察產(chǎn)氣,無需轉(zhuǎn)接BGLB進行確認試驗,可使檢測流程縮短24 h~48 h。適用性廣,可用于各類食品及食品原料。讓您的檢測過程更準確、高效、快速、便捷!